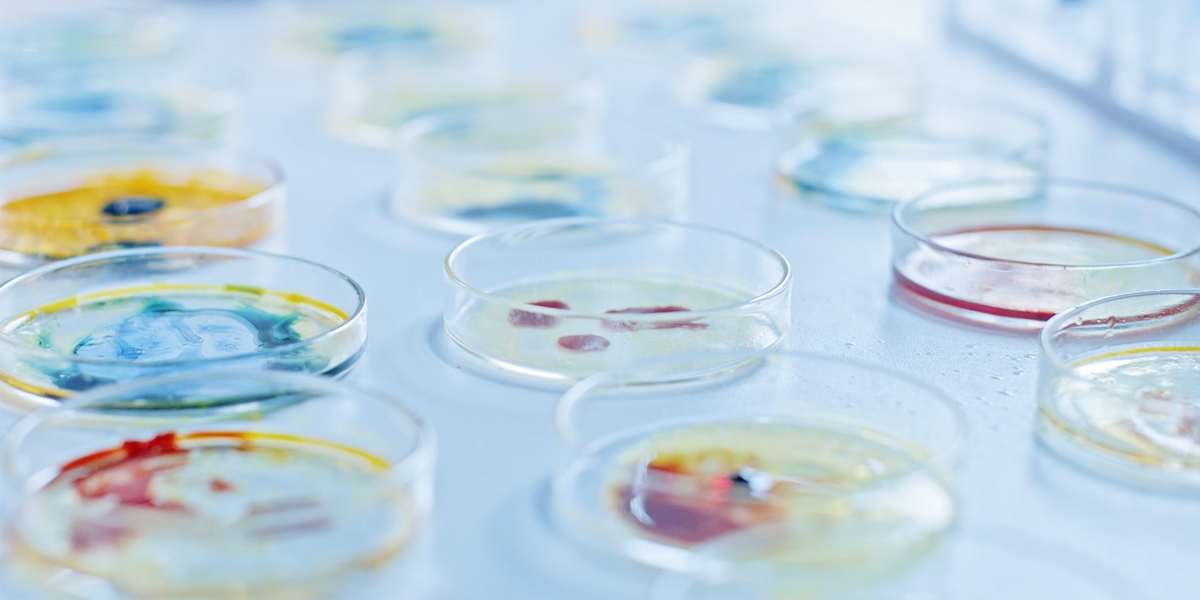

Η ΙΣΤΟΡΙΑ ΜΑΣ
Η ιστορία της Cosmochem Chemicals ξεκινάει από το 1960 και συνεχώς εξελίσσεται.
Ανακαλύψτε τις χρονιές κλειδιά που συνέβαλαν στην κατάκτηση της ηγέτιδας θέσης της εταιρείας στον κλάδο.
Η ιστορία της Cosmochem Chemicals ξεκινάει από το 1960 και συνεχώς εξελίσσεται.
Ανακαλύψτε τις χρονιές κλειδιά που συνέβαλαν στην κατάκτηση της ηγέτιδας θέσης της εταιρείας στον κλάδο.
Σύσταση της εταιρείας με την επωνυμία «Κυριάκος Γιαλαντζής» με δραστηριότητα την παροχή υλικών συσκευασίας.

Παροχή πρώτων υλών στον κλάδο των καλλυντικών.

Μετονομασία της εταιρείας σε Cosmochem Chemicals και επέκταση της δραστηριότητάς της στον κλάδο των πρώτων υλών προϊόντων προσωπικής φροντίδας.

Δημιουργία νέων εγκαταστάσεων αποθήκευσης (4.000m2).

Επέκταση των δραστηριοτήτων της εταιρείας στους τομείς των απορρυπαντικών και των χρωμάτων.
Έναρξη και δικτύωση στις εξαγωγές πρώτων υλών χημικών προϊόντων.


Έχουμε συντάξει την Πολιτική Απορρήτου και Πολιτική Cookies, αναφορικά με την από μέρους μας μεταχείριση των προσωπικών σας δεδομένων και σύμφωνα με τον Γενικό Κανονισμό Προστασίας Προσωπικών Δεδομένων (ΕΕ) 2016/679 που ορίζει τις πληροφορίες που δικαιούμαστε να συλλέγουμε, τον τρόπο από μέρους μας χρήσης αυτών των πληροφοριακών δεδομένων και την ενημέρωσή σας σχετικά με τις επιλογές που έχετε με τη μετάβασή σας στον παρόντα ιστότοπο.
Για τους σκοπούς της παροχής των επαγγελματικών υπηρεσιών της, η Εταιρεία δύναται να προχωρήσει στη συλλογή και την επεξεργασία δεδομένων προσωπικού χαρακτήρα φυσικών προσώπων σύμφωνα με την ισχύουσα ελληνική νομοθεσία, καθώς και τον Κανονισμό (ΕΕ) 2016/679 του Ευρωπαϊκού Κοινοβουλίου και του Συμβουλίου της 27ης Απριλίου 2016 αναφορικά με την προστασία των φυσικών προσώπων ως προς την επεξεργασία των δεδομένων προσωπικού χαρακτήρα και την ελεύθερη κυκλοφορία των εν λόγω δεδομένων (Γενικός Κανονισμός Προστασίας Προσωπικών Δεδομένων, εφεξής αναφερόμενος ως “ΓΚΠΠΔ”) και, κατά συνέπεια, δύναται να ενεργεί ως “υπεύθυνος επεξεργασίας δεδομένων“.
Στόχος της παρούσας Πολιτικής Απορρήτου είναι η αποσαφήνιση των πρακτικών επεξεργασίας δεδομένων προσωπικού χαρακτήρα που εφαρμόζουμε, επεξηγώντας τους τύπους των προσωπικών δεδομένων ή άλλων πληροφοριών που μπορούν να εξακριβώσουν την ταυτότητα ενός προσώπου και έχουμε τη δυνατότητα να συλλέγουμε κατά τη διάρκεια της χρήσης του ιστότοπου και των υπηρεσιών μας από εσάς, τους τρόπους και τους λόγους για τους οποίους συγκεντρώνουμε τις εν λόγω πληροφορίες, πώς χρησιμοποιούμε τα προσωπικά στοιχεία σας, πότε και σε ποιους ενδέχεται να κοινοποιήσουμε και να αποκαλύψουμε πληροφορίες για το άτομό σας, καθώς και πώς μπορείτε να διαχειρίζεστε τις πληροφορίες που σας αφορούν και να ασκείτε τα δικαιώματά σας, όπως προβλέπονται από τον ΓΚΠΠΔ.
Με την παροχή των δεδομένων προσωπικού χαρακτήρα σε εμάς (μέσω του ιστότοπού μας, μέσω e-mail, αυτοπροσώπως ή μέσω τηλεφώνου), σημαίνει ότι αποδέχεστε την επεξεργασία όπως ορίζεται στην παρούσα Πολιτική Απορρήτου.
Βασικά δεδομένα προσωπικού χαρακτήρα και στοιχεία επικοινωνίας, όπως το ονοματεπώνυμό σας, επαγγελματική ιδιότητα, ταχυδρομική διεύθυνση, διεύθυνση εργασίας, αριθμό τηλεφώνου, αριθμό κινητού τηλεφώνου, αριθμό φαξ και διεύθυνση e-mail. Χρηματοοικονομικά δεδομένα και δεδομένα που σχετίζονται με τη φορολογία, όπως πληροφορίες που σχετίζονται με πληρωμές και είναι απαραίτητες για τη διεκπεραίωση πληρωμών καθώς και την αποτροπή απάτης, όπως στοιχεία τραπεζικού λογαριασμού, αριθμούς πιστωτικών/χρεωστικών καρτών, αριθμούς κωδικών ασφαλείας και άλλα στοιχεία που αφορούν χρεώσεις, ΑΦΜ κ.λπ. Αρχεία επικοινωνίας και επισκέψεών σας στα γραφεία μας. Δεδομένα που σχετίζονται με διαδικασία πρόσληψης, όπως το βιογραφικό σας, το ιστορικό μόρφωσης και απασχόλησής σας, λεπτομέρειες συνδρομών σε επαγγελματικές ενώσεις και άλλες πληροφορίες που σχετίζονται με δυνητική πρόσληψή σας από την Εταιρεία. Δεδομένα χρήσης ιστότοπου, όπως λεπτομέρειες των επισκέψεών σας στον ιστότοπό μας ή πληροφορίες που συλλέγονται μέσω cookies. Τυχόν άλλα δεδομένα προσωπικού χαρακτήρα που σας αφορούν και ενδεχομένως μας παράσχετε. Έχουμε τη δυνατότητα να συλλέγουμε τα δεδομένα προσωπικού χαρακτήρα με διάφορα μέσα και τρόπους.
Συγκεκριμένα:
Μπορείτε να μας παράσχετε απευθείας τα προσωπικά στοιχεία σας, για παράδειγμα με τη συμπλήρωση και την υποβολή μιας φόρμας στον ιστότοπό μας, επικοινωνώντας μαζί μας μέσω e-mail, επιστολής, τηλεφώνου ή αυτοπροσώπως κατά τη διάρκεια επίσκεψης στα γραφεία μας ή με τη συμμετοχή σας σε εκδηλώσεις που διοργανώνουμε. Έχουμε τη δυνατότητα να συλλέγουμε τις πληροφορίες από τρίτες πηγές, όπως όταν λαμβάνουμε πληροφορίες σχετικά με εσάς από συνεργάτες και εξωτερικούς συμβούλους με τους οποίους ενδεχομένως έχετε ήδη κάποια επιχειρηματική σχέση, για σκοπούς περαιτέρω συνεργασίας με την Εταιρεία μας. Έχουμε τη δυνατότητα να συλλέγουμε τις πληροφορίες από δημοσίως διαθέσιμες πηγές.
Συγκεκριμένα, χρησιμοποιούμε τα δεδομένα προσωπικού χαρακτήρα:
Για να παρέχουμε προϊόντα και υπηρεσίες που έχετε ενδεχομένως ζητήσει. Για να διαχειριζόμαστε τις επιχειρησιακές λειτουργίες μας και τις επιχειρηματικές σχέσεις των πελατών μας με εμάς, συμπεριλαμβανομένης της διεκπεραίωσης πληρωμών, της λογιστικής καταγραφής, του ελέγχου, της τιμολόγησης, των υποστηρικτικών υπηρεσιών. Για να αναλύουμε και να βελτιώνουμε τις υπηρεσίες μας και τις επικοινωνίες μας μαζί σας. Για να προστατεύουμε την ασφάλεια και να διαχειριζόμαστε την πρόσβαση στον χώρο μας, τα συστήματα IT, τα συστήματα επικοινωνίας και τον ιστότοπό μας, καθώς και να αποτρέπουμε και να ανιχνεύουμε απειλές για την ασφάλεια, απάτες ή άλλες εγκληματικές ή κακόβουλες δραστηριότητες. Για να διερευνούμε τους σκοπούς και να αποτρέπουμε τη μη εξουσιοδοτημένη πρόσβαση στις υπηρεσίες αλλά και άλλες παράνομες δραστηριότητες. Για να εξακριβώνουμε την ταυτότητα των προσώπων που έχουν εξουσιοδότηση να διενεργούν συναλλαγές εξ ονόματος των πελατών, των προμηθευτών ή/και των παρόχων υπηρεσιών μας. Για να συμμορφωνόμαστε με τις νομικές και κανονιστικές υποχρεώσεις μας, συμπεριλαμβανομένης της λογοδοσίας ή/και της υποβολής σε έλεγχο από εθνικούς και διεθνείς ρυθμιστικούς φορείς. Για να συμμορφωνόμαστε με δικαστικές αποφάσεις ή/και για να υπερασπιζόμαστε τα έννομα δικαιώματά μας. Για να επικοινωνούμε μαζί σας για τις πιο πρόσφατες εξελίξεις, ανακοινώσεις και άλλες πληροφορίες που μας αφορούν μέσω ενημερωτικών δελτίων, συνοπτικών παρουσιάσεων κ.λπ., κατόπιν δική σας ρητής συγκατάθεσης. Για την αξιολόγηση προσόντων και πιθανότητας πρόσληψης στην Εταιρεία μας. Για να διευκολύνουμε την παρουσία σας σε εκδηλώσεις που διοργανώνουμε και να σας προσφέρουμε την κατάλληλη εξυπηρέτηση. Για οποιονδήποτε άλλο σκοπό που σχετίζεται με ή/και συνεπικουρεί σε οποιοδήποτε σημείο εκ των ανωτέρω ή οποιονδήποτε άλλο σκοπό για τον οποίο παρασχέθηκαν τα δεδομένα προσωπικού χαρακτήρα σε εμάς. Τυχόν δυνητικές επικοινωνίες που σχετίζονται με ενέργειες μάρκετινγκ θα διενεργούνται μόνο αφού έχετε επιλέξει την εν λόγω διενέργεια και θα σας δώσουμε την ευκαιρία να εξαιρεθείτε από αυτήν ανά πάσα στιγμή, αν δεν επιθυμείτε να συνεχίσετε να λαμβάνετε επικοινωνίες για ενέργειες μάρκετινγκ από εμάς. Δεν θα χρησιμοποιούμε τα δεδομένα προσωπικού χαρακτήρα για λήψη τυχόν αυτοματοποιημένων αποφάσεων που σας επηρεάζουν άμεσα ή για τη δημιουργία προφίλ διαφορετικών από αυτά που περιγράφονται ανωτέρω.
Τα προσωπικά στοιχεία που διατηρούμε και επεξεργαζόμαστε είναι απαραίτητα για την εκτέλεση της σύμβασης υπηρεσιών μας ή άλλης συμφωνίας, στην οποία οι πελάτες μας είναι συμβαλλόμενα μέρη, ή για την προμήθεια των προϊόντων και την εκτέλεση των υπηρεσιών που οι πελάτες μας έχουν άλλως ζητήσει. Τα προσωπικά στοιχεία που συλλέγουμε και επεξεργαζόμαστε ενδέχεται να είναι επίσης απαραίτητα για τα έννομα επιχειρηματικά ενδιαφέροντά μας, από την άποψη της παροχής των καλύτερων δυνατών λύσεων στους πελάτες μας, της διαχείρισης των καθημερινών επιχειρηματικών μας αναγκών, της παροχής στους υφιστάμενους ή τους υποψήφιους πελάτες μας πληροφοριών σχετικά με τα προϊόντα και τις υπηρεσίες που προσφέρουμε και για τα οποία έχουν εκδηλώσει ενδιαφέρον ή που πιστεύουμε ότι θα είναι προς όφελός τους. Σε ορισμένες περιπτώσεις, η βάση μας για τη συλλογή και την επεξεργασία των πληροφοριών στηρίζεται στη ρητή συγκατάθεσή σας για τη συλλογή και επεξεργασία των προσωπικών στοιχείων σας από εμάς, όπως, για παράδειγμα, όταν επικοινωνούμε μαζί σας όσον αφορά την παροχή σχετικών πληροφοριών μάρκετινγκ, όταν υποβάλετε το βιογραφικό σας προκειμένου να αξιολογηθεί ή για τη συμμετοχή σας σε επιστημονικά συνέδρια και παρόμοιες εκδηλώσεις που διοργανώνουμε. Επίσης, έχουμε τη δυνατότητα να επεξεργαστούμε τα δεδομένα προσωπικού χαρακτήρα για να συμμορφωθούμε με νομική υποχρέωση στην οποία υπόκειται η Εταιρεία μας και για την εκπλήρωση των ρυθμιστικών και κανονιστικών υποχρεώσεων ή δικαστικών ή άλλων εντολών (π.χ. συμμόρφωση με τις φορολογικές διαδικασίες, διαδικασίες αντιμετώπισης της νομιμοποίησης εσόδων από παράνομες δραστηριότητες, ανίχνευση απάτης, εξασφάλιση ιχνηλασιμότητας κ.λπ.).
Έχουμε τη δυνατότητα να κοινοποιούμε τα δεδομένα προσωπικού χαρακτήρα μόνο στις ακόλουθες ενδεικτικές κατηγορίες αποδεκτών:
Τραπεζικά ιδρύματα, ασφαλιστικοί φορείς, δικηγόροι ή άλλοι πάροχοι νομικών υπηρεσιών (συμπεριλαμβανομένων των διαμεσολαβητών), σύμβουλοι ή εμπειρογνώμονες ή άλλοι επαγγελματίες σύμβουλοι, ανάλογα με την εκάστοτε περίπτωση (π.χ. οικονομικοί, επιχειρηματικοί ή άλλοι σύμβουλοι), ελεγκτές, ορκωτοί ελεγκτές λογιστές, επιστημονικοί υπεύθυνοι που απασχολούνται στο πλαίσιο της παροχής των υπηρεσιών στους υπάρχοντες ή υποψήφιους πελάτες μας. Τρίτοι πάροχοι υπηρεσιών στους οποίους αναθέτουμε ορισμένες δραστηριότητες, όπως μεταξύ άλλων υπηρεσίες τεχνολογιών και πληροφορικής, λογιστικές υπηρεσίες, υπηρεσίες μετάφρασης, ταχυδρομικές και μεταφορικές υπηρεσίες. Σε τέτοιες περιπτώσεις, απαιτούμε από όλους αυτούς τους τρίτους παρόχους υπηρεσιών να ενεργούν σύμφωνα με την παρούσα Πολιτική Απορρήτου, τις οδηγίες μας και τους ισχύοντες νόμους περί προστασίας δεδομένων. Δεσμευόμαστε να χρησιμοποιούμε τα κατάλληλα μέτρα προφύλαξης, όπως απαιτείται από την ισχύουσα νομοθεσία, για να διασφαλίζουμε την εμπιστευτικότητα, την ακεραιότητα και την ασφάλεια των δεδομένων προσωπικού χαρακτήρα, σε περίπτωση ανάθεσης εργασιών σε αυτούς τους παρόχους υπηρεσιών. Έχουμε τη δυνατότητα να κοινοποιήσουμε τα δεδομένα προσωπικού χαρακτήρα σε δικαστήρια, κρατικές, ρυθμιστικές ή άλλες δημόσιες αρχές.
Όταν η επεξεργασία των δεδομένων προσωπικού χαρακτήρα σχετίζεται με την θεμελίωση, την άσκηση ή την υπεράσπιση νομικών αξιώσεων, θα διατηρούμε τα δεδομένα προσωπικού χαρακτήρα μέχρι να λήξει η προθεσμία για την ικανοποίηση των αξιώσεων ή μέχρι να διευθετηθούν οι αξιώσεις, ή προκειμένου να συμμορφωθούμε με τις νομικές απαιτήσεις σχετικά με τη διατήρηση τέτοιων δεδομένων.
Επίσης, οι περίοδοι διατήρησης βασίζονται στις επιχειρηματικές μας ανάγκες και τις βέλτιστες πρακτικές.
Εφαρμόζουμε τα κατάλληλα τεχνικά και οργανωτικά μέτρα ασφαλείας, προκειμένου να προστατεύουμε τα δεδομένα προσωπικού χαρακτήρα που έχουμε στην κατοχή μας στα δίκτυα και τα συστήματά μας, ενάντια σε μη εξουσιοδοτημένη πρόσβαση, αποκάλυψη, αλλοίωση, κακή χρήση, απώλεια και καταστροφή. Τα μέτρα ασφαλείας περιλαμβάνουν, ενδεικτικά, φυσικές, τεχνικές, διοικητικές, ηλεκτρονικές και διαδικαστικές διασφαλίσεις, τείχη προστασίας (“firewall”), φυσικούς ελέγχους πρόσβασης στα κέντρα δεδομένων μας και ελέγχους εξουσιοδότησης πρόσβασης στις πληροφορίες. Επίσης, οι διαδικασίες ασφαλείας μας σημαίνουν ότι μπορεί περιστασιακά να ζητήσουμε αποδεικτικά ταυτοποίησης, προκειμένου να εξακριβώσουμε την ταυτότητά σας, πριν την επικοινωνία μας μαζί σας ή προτού αποκαλύψουμε τυχόν προσωπικά στοιχεία σε εσάς.
Αν και καταβάλλουμε κάθε δυνατή προσπάθεια για τη διαφύλαξη των δεδομένων προσωπικού χαρακτήρα, κατά τη διάρκεια της παραλαβής τους και ειδικά για όσα δεδομένα λαμβάνουμε μέσω του ιστοτόπου μας, δεν μπορούμε να εγγυηθούμε για την 100% ασφάλεια της μετάδοσης δεδομένων μέσω του διαδικτύου ή άλλου δημόσιου δικτύου.
Για να δείτε τα δεδομένα που συλλέγει η Google και τους σκοπούς για τους οποίους χρησιμοποιούνται τα εν λόγω δεδομένα, επισκεφτείτε τη διεύθυνση https://www.google.com/intl/en/policies/privacy/.
· ΠΟΛΙΤΙΚΗ ΑΠΟΡΡΗΤΟΥ ΕΝΣΩΜΑΤΩΜΕΝΩΝ ΣΤΟΙΧΕΙΩΝ ΜΕΣΩΝ ΚΟΙΝΩΝΙΚΗΣ ΔΙΚΤΥΩΣΗΣ Ενδέχεται να ενσωματώσουμε στοιχεία υπηρεσιών μέσων κοινωνικής δικτύωσης στον ιστότοπό μας για την προβολή εικόνων, βίντεο και κειμένων. Με τη μετάβαση σε σελίδες όπου εμφανίζονται τα εν λόγω στοιχεία, γίνεται μεταφορά δεδομένων από το πρόγραμμα περιήγησής σας προς την αντίστοιχη υπηρεσία μέσου κοινωνικής δικτύωσης και αποθηκεύονται εκεί. Δεν έχουμε πρόσβαση σε αυτά τα δεδομένα.
Οι ακόλουθοι σύνδεσμοι θα σας κατευθύνουν στις σελίδες των αντίστοιχων υπηρεσιών μέσων κοινωνικής δικτύωσης, όπου θα βρείτε εξηγήσεις σχετικά με τον τρόπο μεταχείρισης των δεδομένων σας:
Πολιτική Απορρήτου του Instagram: https://help.instagram.com/519522125107875 Για το YouTube, ισχύει η Πολιτική Απορρήτου της Google: https://policies.google.com/privacy?hl=en Πολιτική Δεδομένων του Facebook: https://www.facebook.com/about/privacy Πολιτική Απορρήτου του Twitter: https://twitter.com/privacy Πολιτική Απορρήτου του LinkedIn: https://www.linkedin.com/legal/privacy-policy · Πολιτική Απορρήτου του Facebook Σε αυτόν τον ιστότοπο ενδέχεται να χρησιμοποιήσουμε λειτουργίες του Facebook, ενός μέσου κοινωνικής δικτύωσης (Facebook Ireland Ltd., 4 Grand Canal Square, Grand Canal Harbor, Dublin 2, Ιρλανδία).
Μπορείτε να διαβάσετε για τις λειτουργίες (πρόσθετα κοινωνικής δικτύωσης) που παρέχει το Facebook στη σελίδα https://developers.facebook.com/docs/plugins/.
Με τη μετάβαση στον ιστότοπό μας, ενδέχεται να γίνει μετάδοση πληροφοριών στο Facebook. Αν διαθέτετε λογαριασμό στο Facebook, το Facebook μπορεί να συσχετίσει αυτές τις πληροφορίες με τον προσωπικό λογαριασμό σας. Αν δεν επιθυμείτε κάτι τέτοιο, αποσυνδεθείτε από το Facebook.
Μπορείτε να βρείτε την Πολιτική Απορρήτου, τις πληροφορίες που συλλέγει το Facebook και τους τρόπους με τους οποίους τις χρησιμοποιεί στη διεύθυνση https://www.facebook.com/policy.php
· Πολιτική Απορρήτου του Youtube Στον παρόντα ιστότοπο, ενδέχεται να χρησιμοποιήσουμε την υπηρεσία βίντεο YouTube της εταιρείας YouTube, LLC, 901 Cherry Ave., San Bruno, CA 94066, ΗΠΑ.
Με την πρόσβαση στις σελίδες του ιστοτόπου μας όπου υπάρχουν ενσωματωμένα βίντεο YouTube, γίνεται μετάδοση δεδομένων στο YouTube, όπου αποθηκεύονται και αξιολογούνται.
Αν διαθέτετε λογαριασμό στο YouTube και είστε συνδεδεμένοι, αυτές οι πληροφορίες θα συσχετιστούν με τον προσωπικό λογαριασμό σας και τα δεδομένα που αποθηκεύονται σε αυτόν.
Για να δείτε τα δεδομένα που συλλέγει η Google και τους σκοπούς για τους οποίους χρησιμοποιούνται τα εν λόγω δεδομένα, επισκεφτείτε τη διεύθυνση https://www.google.com/intl/en/policies/privacy/
· Πολιτική Απορρήτου του Instagram Στον παρόντα ιστότοπο, ενδέχεται να χρησιμοποιήσουμε λειτουργίες του μέσου κοινωνικής δικτύωσης Instagram (Instagram LLC, 1601 Willow Rd, Menlo Park CA 94025, ΗΠΑ).
Μπορούμε να προβάλλουμε εικόνες και βίντεο περιεχομένου του Instagram μέσω της λειτουργικότητας ενσωμάτωσης.
Με τη μετάβαση σε σελίδες που χρησιμοποιούν ανάλογες λειτουργίες, γίνεται μετάδοση δεδομένων (διεύθυνση IP, δεδομένα προγράμματος περιήγησης, ημερομηνία, ώρα, cookies) στο Instagram, όπου αποθηκεύονται και αξιολογούνται.
Αν διαθέτετε λογαριασμό στο Instagram και είστε συνδεδεμένοι, αυτές οι πληροφορίες θα συσχετιστούν με τον προσωπικό λογαριασμό σας και τα δεδομένα που αποθηκεύονται σε αυτόν.
Μπορείτε να βρείτε την Πολιτική Απορρήτου σχετικά με τη συλλογή πληροφοριών από το Instagram και τους τρόπους με τους οποίους τις χρησιμοποιεί στη διεύθυνση help.instagram.com/519522125107875
· Πολιτική Απορρήτου του LinkedIn Στον ιστότοπό μας, ενδέχεται να χρησιμοποιήσουμε λειτουργίες του μέσου κοινωνικής δικτύωσης LinkedIn (LinkedIn Corporation, 2029 Stierlin Court, Mountain View, CA 94043, ΗΠΑ).
Με τη μετάβαση σε σελίδες που χρησιμοποιούν ανάλογες λειτουργίες, γίνεται μετάδοση δεδομένων (διεύθυνση IP, δεδομένα προγράμματος περιήγησης, ημερομηνία, ώρα, cookies) στο LinkedIn, όπου αποθηκεύονται και αξιολογούνται.
Αν διαθέτετε λογαριασμό στο LinkedIn και είστε συνδεδεμένοι, αυτές οι πληροφορίες θα συσχετιστούν με τον προσωπικό λογαριασμό σας και τα δεδομένα που αποθηκεύονται σε αυτόν.
Μπορείτε να βρείτε την Πολιτική Απορρήτου σχετικά με τη συλλογή πληροφοριών από το LinkedIn και τους τρόπους με τους οποίους τις χρησιμοποιεί στη διεύθυνση www.linkedin.com/legal/privacy-policy
· Πολιτική Απορρήτου του Facebook Pixel Σε αυτόν τον ιστότοπο ενδέχεται να χρησιμοποιήσουμε λειτουργίες Facebook Pixel του Facebook, ενός μέσου κοινωνικής δικτύωσης (Facebook Ireland Ltd., 4 Grand Canal Square, Grand Canal Harbor, Dublin 2, Ιρλανδία).
Ο κώδικας που είναι ενσωματωμένος στη συγκεκριμένη σελίδα μπορεί να αξιολογεί τη συμπεριφορά των επισκεπτών που έχουν οδηγηθεί στον παρόντα ιστότοπο από μια διαφήμιση του Facebook. Αυτό μπορεί να χρησιμοποιηθεί για τη βελτίωση των διαφημίσεων του Facebook και τα εν λόγω δεδομένα συλλέγονται και αποθηκεύονται από το Facebook. Δεν έχουμε δικαίωμα εμφάνισης των συλλεγόμενων δεδομένων, καθώς μπορούν να χρησιμοποιηθούν μόνο στο πλαίσιο των διαφημίσεων. Με τη χρήση του κώδικα Facebook Pixel, ορίζονται επίσης και cookies.
Με τη χρήση του Facebook Pixel, η μετάβαση στον ιστότοπό μας κοινοποιείται στο Facebook, για να μπορούν οι επισκέπτες να βλέπουν κατάλληλες διαφημίσεις στο Facebook. Αν διαθέτετε λογαριασμό στο Facebook και είστε συνδεδεμένοι, η μετάβαση στον παρόντα ιστότοπο θα συσχετιστεί με τον λογαριασμό χρήστη στο Facebook.
Για να μάθετε πώς χρησιμοποιείται το Facebook Pixel σε διαφημιστικές καμπάνιες, επισκεφτείτε τη σελίδα https://www.facebook.com/business/learn/facebook-ads-pixel.
Μπορείτε να αλλάξετε τις ρυθμίσεις διαφημίσεων του Facebook από τη σελίδα https://www.facebook.com/ads/preferences/?entry_product=ad_settings_screen, εφόσον είστε συνδεδεμένοι στο Facebook.
Από τη διεύθυνση http://www.youronlinechoices.com/ μπορείτε να διαχειρίζεστε τις προτιμήσεις σας σχετικά με τις διαδικτυακές διαφημίσεις βάσει χρήσης. Μπορείτε να απενεργοποιήσετε ή να ενεργοποιήσετε πολλούς παρόχους μεμιάς ή να αλλάξετε ρυθμίσεις για μεμονωμένους παρόχους.
Μπορείτε να βρείτε περισσότερες πληροφορίες σχετικά με την πολιτική δεδομένων του Facebook στη διεύθυνση https://www.facebook.com/policy.php.
Μπορείτε να εξακριβώνετε ότι χρησιμοποιείται το εν λόγω μέτρο προφύλαξης για τη μεταφορά δεδομένων αναζητώντας το μικρό σύμβολο λουκέτου στην επάνω αριστερή γωνία του προγράμματος περιήγησης, καθώς και ότι χρησιμοποιείται η μορφή https (αντί του http) ως μέρος της διαδικτυακής μας διεύθυνσης.
Δεν χρειάζεται να είστε συνδεδεμένοι ή να έχετε κωδικό πρόσβασης για να χρησιμοποιήσετε το Google Fonts. Επιπλέον, δεν αποθηκεύονται cookies στο πρόγραμμα περιήγησής σας.
Τα αρχεία (CSS, γραμματοσειρές) απαιτούνται από τους τομείς Google fonts.googleapis.com και fonts.gstatic.com. Σύμφωνα με την Google, τα αιτήματα για CSS και γραμματοσειρές είναι εξ ολοκλήρου διαχωρισμένα από όλες τις άλλες υπηρεσίες της Google. Αν διαθέτετε λογαριασμό Google, δεν χρειάζεται να ανησυχείτε για την τυχόν αποστολή πληροφοριών του λογαριασμού σας Google προς την Google κατά τη χρήση του Google Fonts. Η Google καταγράφει τη χρήση του CSS (Cascading Style Sheets) και των χρησιμοποιούμενων γραμματοσειρών και αποθηκεύει με ασφάλεια τα εν λόγω δεδομένα. Ας δούμε λεπτομερώς πώς ακριβώς αποθηκεύονται τα δεδομένα.
Πολλές από αυτές τις γραμματοσειρές δημοσιεύονται δυνάμει του SIL Open Font License, ενώ άλλες έχουν εκδοθεί δυνάμει του Apache License. Αμφότερες οι άδειες είναι άδειες ελεύθερου λογισμικού. Ως εκ τούτου, μπορούμε να τις χρησιμοποιούμε δωρεάν χωρίς την καταβολή δικαιωμάτων εκμετάλλευσης.
Ως εκ τούτου, χρησιμοποιούμε το Google Fonts για να κάνουμε την εμφάνιση των online υπηρεσιών μας στο σύνολό τους όσο το δυνατόν πιο ευπαρουσίαστη και συνεπή. Σύμφωνα με το Άρθρο 6 παράγραφος 1 στ του ΓΚΠΠΔ, αυτό αποτελεί “έννομο συμφέρον” όσον αφορά την επεξεργασία δεδομένων προσωπικού χαρακτήρα. Σε αυτήν την περίπτωση, ως “έννομο συμφέρον” νοούνται τα νομικά, οικονομικά ή ιδεατά συμφέροντα που αναγνωρίζονται από το νομικό σύστημα.
Το Google Fonts αποθηκεύει με ασφάλεια τα αιτήματα CSS και γραμματοσειράς στην Google και, έτσι, είναι προστατευμένα. Μέσω της συλλογής των στατιστικών χρήσης, η Google μπορεί να προσδιορίζει τη δημοφιλία των γραμματοσειρών. Η Google δημοσιεύει τα αποτελέσματα σε σελίδες εσωτερικής ανάλυσης, όπως το Google Analytics. Επιπλέον, η Google χρησιμοποιεί και δεδομένα χρηστών από το δικό της πρόγραμμα ανίχνευσης web, για να προσδιορίζει τους ιστότοπους που χρησιμοποιούν το Google Fonts. Αυτά τα δεδομένα δημοσιεύονται στη βάση δεδομένων BigQuery του Google Fonts. Το BigQuery είναι μια υπηρεσία web της Google για εταιρείες που θέλουν να μετακινούν και να αναλύουν μεγάλους όγκους δεδομένων.
Ωστόσο, θα πρέπει να ληφθεί υπόψη ότι κάθε αίτημα Google Font θα μεταφέρει επίσης αυτόματα πληροφορίες, όπως διεύθυνση IP, ρυθμίσεις γλώσσας, ανάλυση οθόνης προγράμματος περιήγησης, έκδοση και όνομα προγράμματος περιήγησης στους διακομιστές της Google. Δεν είναι σαφές ή δεν δηλώνεται με σαφήνεια από την Google κατά πόσο αποθηκεύονται και τα εν λόγω δεδομένα.
Χρησιμοποιούμε μια διαδικασία διπλής δήλωσης σύμφωνης γνώμης, έτσι ώστε να λαμβάνετε μόνο τα e-mail που έχετε συμφωνήσει να λαμβάνετε από εμάς. Για να μπορέσει ένας δυνητικός συνδρομητής να εγγραφεί σε ένα ενημερωτικό δελτίο, θα πρέπει να ολοκληρώσει όλα τα βήματα αυτής της διαδικασίας. Αυτή η διαδικασία ολοκληρώνεται όταν ένας χρήστης κάνει κλικ στον σύνδεσμο επιβεβαίωσης στο e-mail διπλής δήλωσης σύμφωνης γνώμης. Η διεύθυνση e-mail του ενεργοποιείται στη λίστα επαφών μόνο αφότου έχει επιβεβαιώσει τη συνδρομή του.
Χρησιμοποιούμε αυτά τα δεδομένα αποκλειστικά για την αποστολή των πληροφοριών και των προσφορών που έχετε ζητήσει.
Το MailChimp είναι η πλατφόρμα ηλεκτρονικής αλληλογραφίας μάρκετινγκ που χρησιμοποιούμε. Αυτό σημαίνει ότι τα στοιχεία σας μεταδίδονται στην εταιρεία MailChimp-c/o The Rocket Science Group, LLC. Απαγορεύεται στο MailChimp η πώληση των δεδομένων σας, καθώς και η χρήση τους για σκοπούς πέραν της αποστολής ηλεκτρονικής αλληλογραφίας. Το MailChimp υποβάλλεται ετησίως σε επαλήθευση από τρίτο εξωτερικό ελεγκτή συμμόρφωσης με έδρα τις ΗΠΑ, σύμφωνα με το πρόγραμμα επαλήθευσης Privacy Shield (ασπίδα προστασίας της ιδιωτικής ζωής), και έχει πιστοποιήσει τη συμμόρφωσή του σύμφωνα με τα νομικά πλαίσια EU-U.S. Privacy Shield (ασπίδα προστασίας της ιδιωτικής ζωής ΕΕ–ΗΠΑ) και Swiss-U.S. Privacy Shield (ασπίδα προστασίας της ιδιωτικής ζωής Ελβετίας–ΗΠΑ).
Περισσότερες πληροφορίες: https://mailchimp.com/about/security/
Όταν μας παραχωρείτε άδεια για την αποθήκευση της διεύθυνσης e-mail σας και την αποστολή ηλεκτρονικής αλληλογραφίας μάρκετινγκ, μπορείτε να ανακαλέσετε αυτήν τη συγκατάθεση ανά πάσα στιγμή μέσω του συνδέσμου κατάργησης εγγραφής που βρίσκεται στο κάτω μέρος κάθε e-mail που λαμβάνετε.
Έχετε το δικαίωμα πρόσβασης στα δεδομένα προσωπικού χαρακτήρα που υποβάλλονται σε επεξεργασία από εμάς και, αν είναι απαραίτητο, να λάβετε ένα αντίγραφο των δεδομένων ή/και συμπληρωματικές πληροφορίες σε σχέση με την επεξεργασία τους.
Δικαίωμα διόρθωσης (Άρθρο 16 του ΓΚΠΠΔ):
Αν τα προσωπικά στοιχεία που έχουμε για εσάς είναι ανακριβή ή ελλιπή, έχετε το δικαίωμα να τα διορθώσετε, να τα ενημερώσετε ή να τα τροποποιήσετε, επικοινωνώντας μαζί μας στα παραπάνω στοιχεία επικοινωνίας. Εναλλακτικά, μπορείτε να μας στείλετε ένα σχετικό αίτημα στην ακόλουθη διεύθυνση e-mail: dpo@cosmochemchemicals.gr
Δικαίωμα διαγραφής (“δικαίωμα στη λήθη”) (Άρθρο 17 του ΓΚΠΠΔ):
Έχετε το δικαίωμα να μας ζητήσετε να διαγράψουμε ή να αφαιρέσουμε τα προσωπικά σας στοιχεία σε ορισμένες περιπτώσεις, όπως όταν δεν τα χρειαζόμαστε πλέον ή εάν ανακαλέσετε τη συγκατάθεσή σας (όπου εφαρμόζεται).
Δικαίωμα περιορισμού της επεξεργασίας (Άρθρο 18 του ΓΚΠΠΔ):
Έχετε το δικαίωμα να ζητήσετε τον περιορισμό της επεξεργασίας των δεδομένων προσωπικού χαρακτήρα σε ορισμένες περιπτώσεις, όπως όταν αμφισβητείτε την ακρίβεια των δεδομένων προσωπικού χαρακτήρα ή όταν η επεξεργασία είναι παράνομη και προβάλλετε αντιρρήσεις για τη διαγραφή των δεδομένων προσωπικού χαρακτήρα και ζητάτε τον περιορισμό της επεξεργασίας τους, αντί της διαγραφής τους, όταν τα δεδομένα προσωπικού χαρακτήρα δεν απαιτούνται για τους σκοπούς της επεξεργασίας, ωστόσο, απαιτούνται για την αναγνώριση, άσκηση ή υπεράσπιση νομικής αξίωσης, και όταν φέρετε αντιρρήσεις για την επεξεργασία και εν αναμονή της επαλήθευσης αν οι δικοί μας έννομοι λόγοι επεξεργασίας υπερισχύουν των δικών σας δικαιωμάτων.
Δικαίωμα εναντίωσης στην επεξεργασία (Άρθρο 21 του ΓΚΠΠΔ):
Έχετε το δικαίωμα να εναντιωθείτε ανά πάσα στιγμή στην επεξεργασία των δεδομένων προσωπικού χαρακτήρα στις περιπτώσεις όπου απαιτείται για τους σκοπούς έννομων συμφερόντων που επιδιώκουμε ως υπεύθυνοι επεξεργασίας δεδομένων.
Δικαίωμα στη φορητότητα των δεδομένων (Άρθρο 20 του ΓΚΠΠΔ):
Έχετε το δικαίωμα, σε ορισμένες περιπτώσεις, να αποκτήσετε τα προσωπικά στοιχεία που έχετε δώσει σε εμάς σε ένα δομημένο, κοινώς χρησιμοποιούμενο και αναγνώσιμο από μηχανήματα μορφότυπο και να τα διαβιβάσετε σε άλλον υπεύθυνο επεξεργασίας δεδομένων για να τα επαναχρησιμοποιήσει ή να ζητήσετε από εμάς να τα μεταφέρουμε σε τρίτους.
Δικαίωμα ανάκλησης της συγκατάθεσης:
Αν βασιζόμαστε στη συγκατάθεσή σας ως έννομη βάση για την επεξεργασία των δεδομένων προσωπικού χαρακτήρα, έχετε το δικαίωμα να ανακαλέσετε την συγκατάθεση ανά πάσα στιγμή. Ωστόσο, θα πρέπει να σημειωθεί ότι η ανάκληση της συγκατάθεσης δεν επηρεάζει τη νομιμότητα της επεξεργασίας που βασίστηκε στη συγκατάθεση κατά την περίοδο πριν την ανάκληση.
Δικαίωμα υποβολής καταγγελίας στην Αρχή Προστασίας Δεδομένων Προσωπικού Χαρακτήρα:
Για να ασκήσετε οποιαδήποτε από τα ως άνω δικαιώματά σας, έχετε το δικαίωμα να υποβάλετε καταγγελία στην Αρχή Προστασίας Δεδομένων Προσωπικού Χαρακτήρα (www.dpa.gr), τηλέφωνο: +30 210 6475600, φαξ: +30 210 6475628, διεύθυνση e-mail: contact@dpa.gr
Σε περίπτωση τυχόν τέτοιων αλλαγών, θα δημοσιεύσουμε την ενημερωμένη Πολιτική Απορρήτου στον ιστότοπό μας. Οι αλλαγές θα τίθενται σε ισχύ από τη στιγμή της δημοσίευσής τους στον παρόντα ιστότοπο. Ως εκ τούτου, σας συνιστούμε να ανατρέχετε στην Πολιτική Απορρήτου όταν επισκέπτεστε τον ιστότοπο για να παραμένετε ενήμεροι σχετικά με το πώς μεταχειριζόμαστε και επεξεργαζόμαστε τα δεδομένα προσωπικού χαρακτήρα.
Επιπλέον, τα μέτρα προστασίας δεδομένων υπόκεινται πάντα σε τεχνολογικές καινοτομίες. Συνεπώς, σας προτρέπουμε να ενημερώνεστε για τα μέτρα προστασίας δεδομένων που εφαρμόζουμε ανά τακτά χρονικά διαστήματα ανατρέχοντας στην πολιτική περί προστασίας δεδομένων που περιλαμβάνεται στο παρόν.